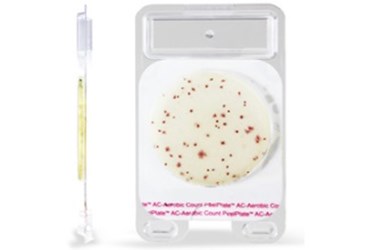
per

Charm Peel Plate AC (Aerobic Count) Microbial Test Receives AOAC-RI Approval
Aerobic count bacterial tests to be debuted at IAFP for use by microbiological laboratories, farmers, milk processors and water municipalities.
Lawrence, MA (PRWEB) - Charm Sciences, Inc. is pleased to announce that the newly developed Peel Plate® AC (Aerobic Count) microbial test has received AOAC Research Institute approval 071501.
“This is the second AOAC-RI approval of a Peel Plate product in less than 1 month,” stated Bob Salter, Vice President of Regulatory and Industrial Affairs. “The Peel Plate methods perform comparably to traditional microbial methods which have led to their rapid performance verifications by AOAC-RI and National Conference of Interstate Milk Shippers laboratories since April 2015. We look forward to showing the product and reference method comparison data to attendees of International Association of Food Protection at the end of July.”
Peel Plate bacterial tests are simplified culture methods developed for microbiologists, food, and water quality stakeholders. Using traditional standard plate count formulation with red producing TTC enzyme substrate, aerobic bacteria produce red spots that are quantified over the 24-48 hour incubation and are used as spoilage and hygienic indicators by food manufacturers. The technology of the Peel Plate AC test is a dried medium in a shallow 47 mm plate that automatically diffuses a liquid sample when added to the plate, and, like conventional plates, allows for picking of cultured organisms for further identification. Simple procedure, convenient stackable design and a formulation resistant to sample pH effects, are all advantages laboratory technicians welcome.
About Charm Sciences, Inc.
Charm Sciences is a world leader provider of food safety, water quality and environmental diagnostics. Charm’s diagnostics portfolio includes test kits and systems for antibiotics, mycotoxins, pesticides, alkaline phosphatase, pathogens, end product microbial assessment, allergen control, water quality and ATP hygiene. Directly and through its network of distributors, Charm products serve the food, beverage, water, pharmaceutical, medical, personal care, environmental, and industrial markets in more than 100 countries. Customers rely on Charm products for excellence in quality, innovation and customer support.
Source: PRWeb
View original release here: http://www.prweb.com/releases/2015/07/prweb12849840.htm